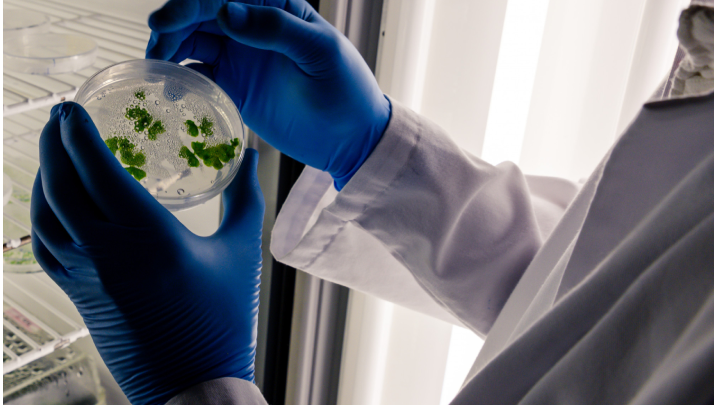
Environmental scientist measuring air pollution levels with handheld device in industrial area

Environmental Testing Services

Reliable Testing for Water, Soil, Air, Mold & More
At Testhub Laboratories, UAE, we provide complete environmental testing services that make sure safety, compliance, and peace of mind. Our certified environmental testing laboratory offers reliable and fast analysis for businesses, corporates, and individuals concerned about the air or water quality of their surroundings.
With advanced modern equipment and experienced staff, from environmental water testing to indoor environmental testing, we offer a full range of environmental testing solutions.
What Is Environmental Testing?
Environmental testing is the process of analyzing environmental samples (like water, soil, air, and waste) to find pollutants, contaminants, and health hazards. It plays an important role in environmental monitoring tests, helping industries and communities follow environmental regulations and maintain a safe living environment.
Features
- Accredited environmental testing laboratories with advanced modern equipment
- Complete services including water, soil, air, and mold testing
- On-site sampling and reliable testing service across the UAE
- Expert team with industry-specific testing knowledge
- Detailed reporting with detectable and verified data
Benefits
- Make sure safety with local and international environmental regulations
- Promotes healthier living and working environments
- Helps find and prevent contamination risks early
- Supports sustainable practices in construction, industry, and agriculture
- Provides peace of mind through clear, actionable test results


Our Environmental Testing Services
We provide tailored environmental testing and consulting across different categories:
1. Water & Wastewater Testing
Our environmental water testing makes sure that both drinking water and wastewater meet local and international safety standards. We test for:
- Heavy metals
- Microorganisms
- pH and chemical contaminants
- Salinity and turbidity
2. Soil & Sludge Testing
Our environmental soil testing helps you understand the fertility and contamination levels of your land. This is important for agriculture, landscaping, and construction. We also analyze sludge from industrial and sewage plants to find its impact on the environment.
3. Microbial Environmental Monitoring
This service is important for industries like food production, pharmaceuticals, and healthcare. We test for airborne and surface microbes, ensuring that your facilities meet hygiene standards.
4. Corrosion Testing
We analyze how materials perform under environmental conditions, helping industries protect infrastructure and equipment. This testing is mainly important for marine and oil industries in the UAE.

Indoor & Air Quality Testing
We offer environmental air testing and indoor environmental testing to measure air quality in homes, offices, and industrial units. We test for:
- PM2.5 and PM10 (fine dust)
- VOCs (Volatile Organic Compounds)
- Carbon dioxide, carbon monoxide
- Mold and microbial content
These tests are important for people with allergies, asthma patients, and for a healthy living.
Accredited Environmental Testing Laboratories
We’re one of the leading environmental testing laboratories in the UAE. We follow Global standards for sampling, testing, and reporting. Every test we conduct is detectable, verified, and delivered with full transparency.
Types of Environmental Testing We Offer
- Environmental water testing
- Environmental soil testing
- Environmental air testing
- Microbial environmental monitoring
- Environmental mold testing
- Indoor environmental testing
- Element environmental testing
- Corrosion and materials testing
- Food and environmental allergy testing


Why Choose Testhub Laboratories?
We are one of the most trusted environmental testing companies in the UAE because we offer:
- Certified environmental testing labs with advanced equipments
- Quick results
- Expert reports with actionable suggestions
- Complete environmental testing and consulting
Whether you’re a homeowner needing home environmental testing or a manufacturer concerned about air or soil quality, Testhub is your best solution.
Faqs
Environmental testing methods include air sampling, water analysis, soil testing, microbial monitoring, and mold detection using lab instruments and field devices.
Environmental services include testing, consulting, and monitoring of air, water, soil, and indoor spaces to find pollution and ensure safety which helps to prevent risks early.
Environmental testing works by collecting samples from your environment (like air, water, or soil) and examining them in environmental testing laboratories.
It helps to detect harmful contaminants, supports public health, and makes sure regulatory compliance through reliable environmental testing services.
Basic procedures include sample collection, lab analysis, and reporting results for The basic procedures environmental water testing, soil testing, and air quality testing.
IEC standards make sure that environmental testing solutions for electrical and electronic equipment are strong and reliable with different environmental conditions.
With ISO 14001, organizations can implement reliable environmental monitoring and management systems that drive long-term sustainability.
The three main types of environmental standards are emission standards, atmospheric quality standards, and effluent standards, all monitored through environmental testing and consulting
